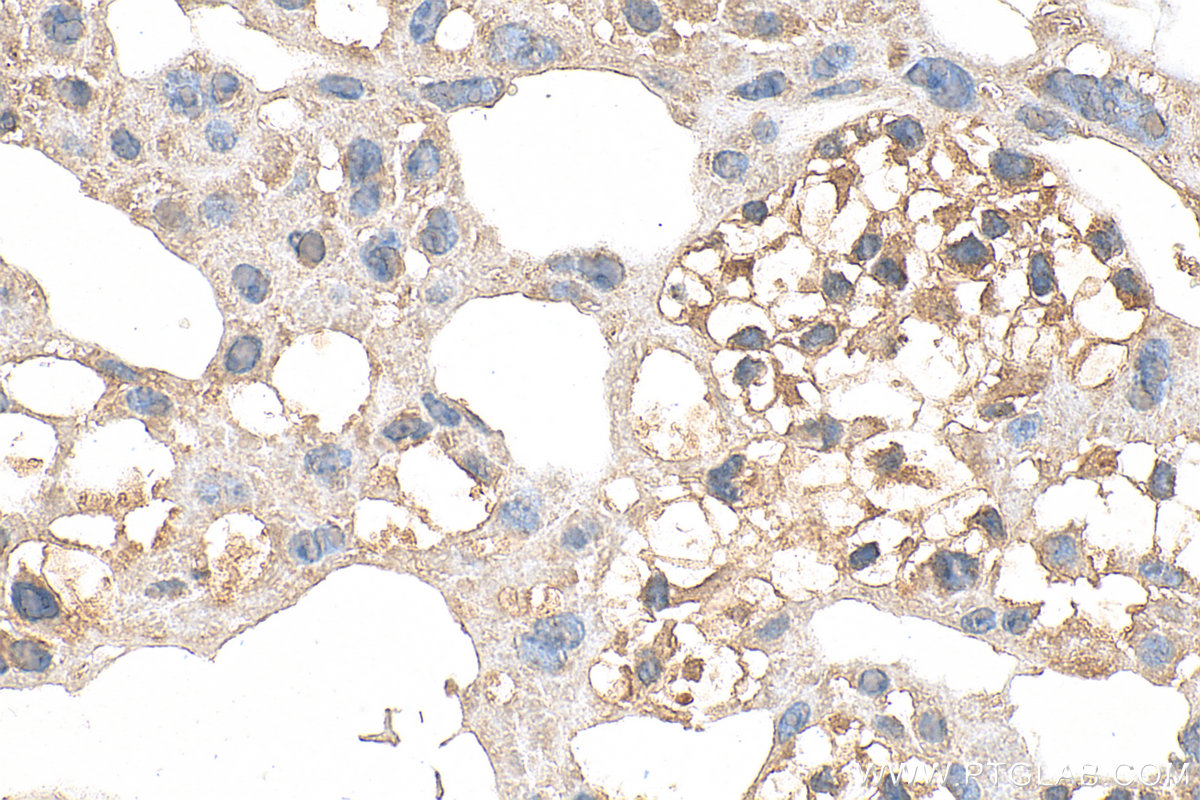
IHC staining of mouse placenta using 30023-1-AP

验证数据展示
经过测试的应用
| Positive WB detected in | mouse brain tissue, rat brain tissue |
| Positive IHC detected in | mouse brain tissue, mouse placenta tissue Note: suggested antigen retrieval with TE buffer pH 9.0; (*) Alternatively, antigen retrieval may be performed with citrate buffer pH 6.0 |
| Positive IF-P detected in | human placenta tissue |
| Positive FC (Intra) detected in | PC-3 cells |
推荐稀释比
| 应用 | 推荐稀释比 |
|---|---|
| Western Blot (WB) | WB : 1:500-1:1000 |
| Immunohistochemistry (IHC) | IHC : 1:300-1:1200 |
| Immunofluorescence (IF)-P | IF-P : 1:50-1:500 |
| Flow Cytometry (FC) (INTRA) | FC (INTRA) : 0.40 ug per 10^6 cells in a 100 µl suspension |
| It is recommended that this reagent should be titrated in each testing system to obtain optimal results. | |
| Sample-dependent, Check data in validation data gallery. | |
发表文章中的应用
| KD/KO | See 1 publications below |
| WB | See 2 publications below |
产品信息
30023-1-AP targets Noggin in WB, IHC, IF-P, FC (Intra), ELISA applications and shows reactivity with human, mouse, rat samples.
| 经测试应用 | WB, IHC, IF-P, FC (Intra), ELISA Application Description |
| 文献引用应用 | WB |
| 经测试反应性 | human, mouse, rat |
| 文献引用反应性 | human, mouse |
| 免疫原 |
CatNo: Ag32755 Product name: Recombinant human NOG protein Source: e coli.-derived, PGEX-4T Tag: GST Domain: 28-145 aa of BC034027 Sequence: QHYLHIRPAPSDNLPLVDLIEHPDPIFDPKEKDLNETLLRSLLGGHYDPGFMATSPPEDRPGGGGGAAGGAEDLAELDQLLRQRPSGAMPSEIKGLEFSEGLAQGKKQRLSKKLRRKL 种属同源性预测 |
| 宿主/亚型 | Rabbit / IgG |
| 抗体类别 | Polyclonal |
| 产品类型 | Antibody |
| 全称 | noggin |
| 别名 | NOG, SYM1, SYNS1 |
| 计算分子量 | 26 kDa |
| 观测分子量 | 32 kDa, 64 kDa |
| GenBank蛋白编号 | BC034027 |
| 基因名称 | Noggin |
| Gene ID (NCBI) | 9241 |
| RRID | AB_2935501 |
| 偶联类型 | Unconjugated |
| 形式 | Liquid |
| 纯化方式 | Antigen affinity purification |
| UNIPROT ID | Q13253 |
| 储存缓冲液 | PBS with 0.02% sodium azide and 50% glycerol, pH 7.3. |
| 储存条件 | Store at -20°C. Stable for one year after shipment. Aliquoting is unnecessary for -20oC storage. |
背景介绍
Noggin is an extracellular polypeptide acting as an antagonist of bone morphogenetic proteins (BMPs) regulating embryonal development. Noggin inhibits activity of BMP-2, -4, -7, -13, and -14. Noggin is present extracellularly in the matrix or retained at the cell surface via interaction with heparin sulfate proteoglycans. In early development stages, Noggin is produced by the Spemann organizer, allowing dorsal-ventral patterning of BMPs (PMID: 8752214). Subsequently, Noggin is expressed by the notochord regulating BMP-4 signaling in neurogenesis. Additionally, Noggin is present during development in the dermal papilla, connective tissue of the hair follicle, lens, retina, and periocular mesenchyme, as well as in the mesoderm lineage regulating development of the bone, cartilage, and muscles.
实验方案
| Product Specific Protocols | |
|---|---|
| FC protocol for Noggin antibody 30023-1-AP | Download protocol |
| IF protocol for Noggin antibody 30023-1-AP | Download protocol |
| IHC protocol for Noggin antibody 30023-1-AP | Download protocol |
| WB protocol for Noggin antibody 30023-1-AP | Download protocol |
| Standard Protocols | |
|---|---|
| Click here to view our Standard Protocols |
发表文章
| Species | Application | Title |
|---|---|---|
J Nanobiotechnology Exosomes derived from mouse vibrissa dermal papilla cells promote hair follicle regeneration during wound healing by activating Wnt/β-catenin signaling pathway | ||
Discov Oncol A novel prognostic risk score associated with resistance to docetaxel chemotherapy for predicting biochemical recurrence-free survival in patients with prostate cancer.
|